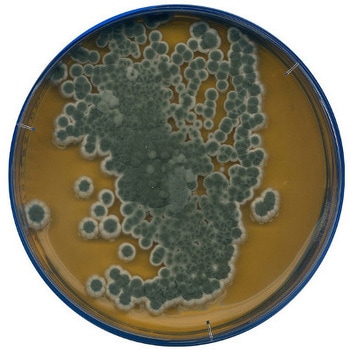

バイオ・食品(菌)関連用品 の新着商品
カテゴリ



商品レビュー
よくあるご質問(FAQ)
- 質問:
- 製品の安全データシート(SDS)や有害物質使用制限に関するデータ(RoHS)等の書面が必要ですがどうすれば良いですか。
- 回答:
- お手数ですが下記URLのお問合せフォームよりご依頼ください。
お問合せ種類 *必須の中から必要な書類をお選びご依頼ください。
https://help.monotaro.com/app/ask
書類名)
1:SDS(MSDS)
2:RoHS(2)
3:非該当証明書
4:ChemSHERPA
5:その他(ミルシート・出荷証明書)
2022-04-07